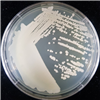

Korean Collection for Type Cultures
KCTC provides the distribution services
Find Resources
KCTC 7647
| KCTC No. | 7647 |
|---|---|
| (KCTC Other No.) | |
| Resource Type | Yeast |
| Name | Candida inconspicua |
| Type Strain | Yes |
| Biosafty Level | 1 |
| LMO | No |
| Synonym | Torulopsis inconspicua |
| Phylum (ex Phylum) | |
| Genome Information | |
| History | <- NRRL |
| Source | From man, water |
| Other Collection No. | ATCC [16783], CBS [180], BCRC [21658], IFO [0621], NRRL [Y-2029], VKM [Y-740] |
| Reference | |
| KCTC Media No. |
KCTC media No. 273 GPYA (Glucose-Peptone-Yeast extract agar) |
| Oxygen Requirement | Aerobic |
| Temperature | 25 ℃ |
| pH | netural pH 배양 가능 (배지정보 참조) |
| Incubation Time | |
| Images |
|
| Price |
[Delivery form & Price]
- Freeze vial (일반 분양) : ₩50,000 KRW - Actively growing culture (활성배양체 분양) : ₩75,000 KRW * 주문시 현재 금액에서 부가가치세 10%가 추가 됩니다 * 동물세포주 일반 분양은 드라이아이스비용(packing charges 20,000원)이 별도로 추가 됩니다. ※ 동물세포주 방문 수령의 경우 별도로 드라이아이스 혹은 액체질소를 가지고 오셔야 합니다. |
| MTA Restrictions | Only NON-COMMERCIAL USE for reference strains and/or academic researches |
| Overseas Export Approval | 본 자원은 국외반출승인대상이 아닙니다. |
If you use the resources sold by our KCTC for papers or patents, please make sure to write the phrase "The biological resources used in this research were distributed from KCTC"




